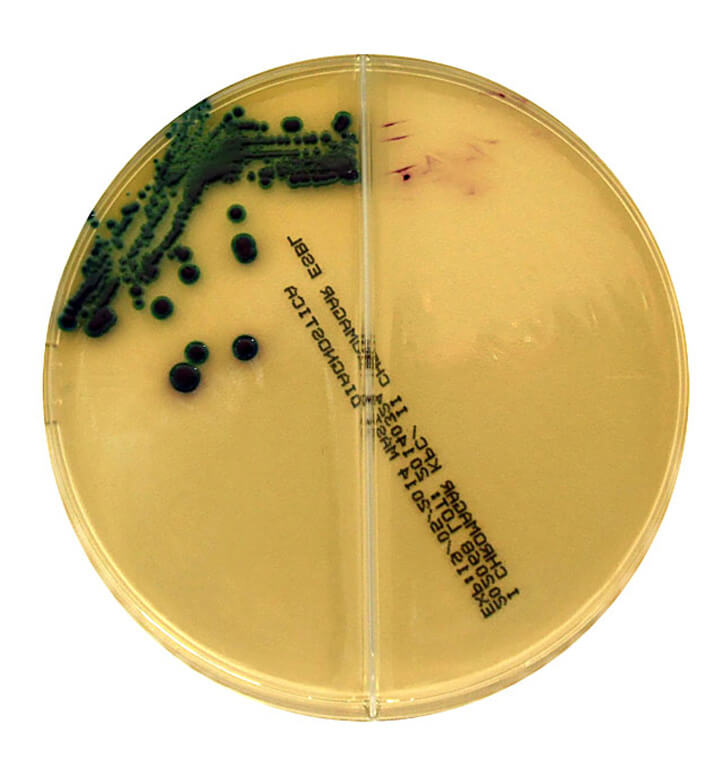

À propos du produit
CHROMagar KPC est utilisé pour la détection et l'isolement sélectif de bactéries Gram négatif avec une sensibilité réduite à la plupart des agents carbapénèmes.
CHROMagar ESBL est utilisé pour l'isolement sélectif et la différenciation des bactéries Gram
négatif produisant des bêta-lactamases à spectre étendu.